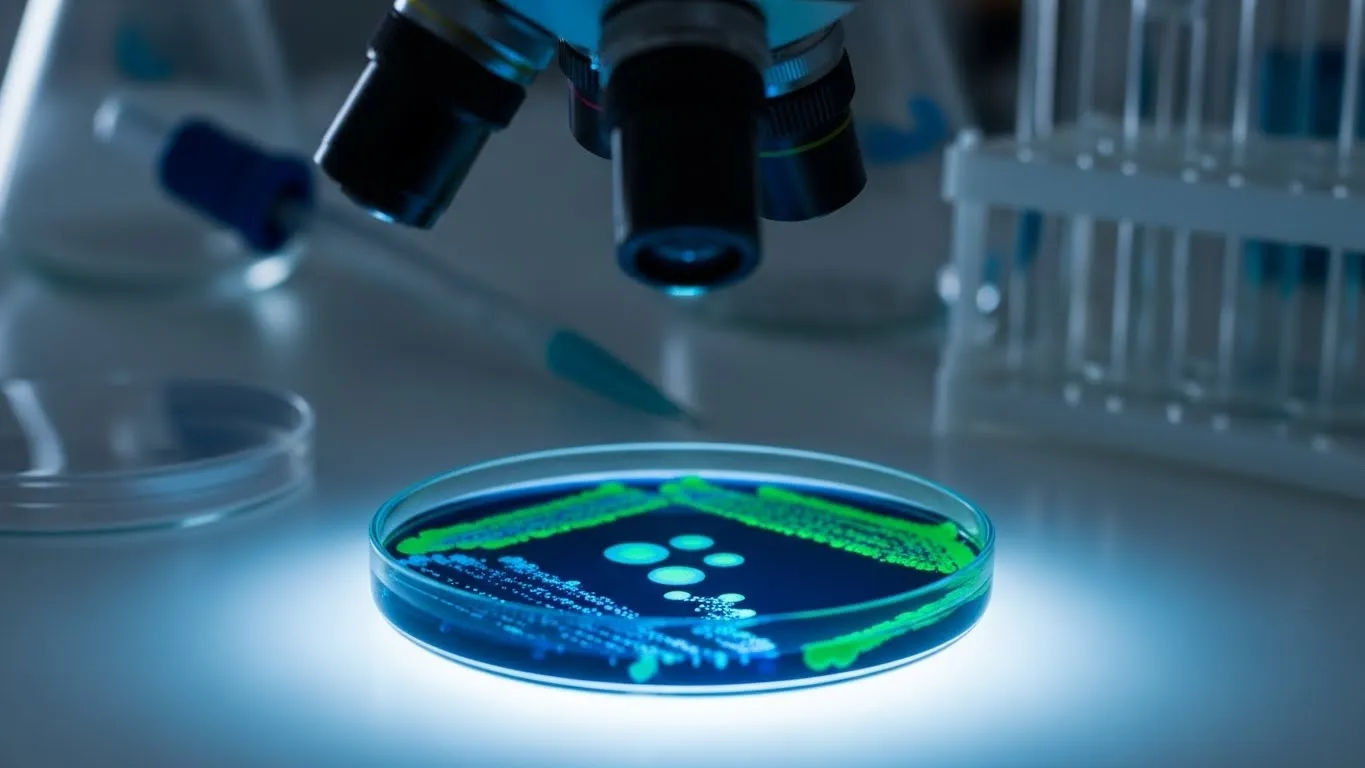
scientific news today

Scientific News Today Urgent Updates

- 1.
What Even Is “Scientific News Today,” Y’all?
- 2.
Hold Up—Why Should We Even Care About Scientific News Today?
- 3.
Peekin’ Under the Hood: What Makes Scientific News Today Tick?
- 4.
Wait—Is All This “Scientific News Today” Actually Trustworthy?
- 5.
What’s Hot in Scientific News Today? Spoiler: It’s Wild
- 6.
From Lab to Living Room: How Scientific News Today Hits Our Daily Lives
- 7.
Y’all Ever Notice How Scientific News Today Feels… Overwhelming?
- 8.
Who’s Actually Reporting Scientific News Today—and Are They Cred?
- 9.
What’s the Deal With Pop Sci vs. Real Scientific News Today?
- 10.
So… How Do We Stay Sane While Tracking Scientific News Today?
Table of Contents
scientific news today
What Even Is “Scientific News Today,” Y’all?
Ever scrolled through your feed at 2 a.m., bleary-eyed and wondering if that glow is your phone or your soul slowly evaporating, only to stumble upon a headline like “Neutrinos Might Be Chatty After All”? That, my friends, is the chaotic magic of scientific news today. It ain’t just lab coats and test tubes—it’s stories about quantum weirdness, climate alarms, and maybe—just maybe—why your dog tilts its head like it’s solving the Riemann hypothesis. Scientific news today is the pulse of what humanity’s wrestling with right this second: the thrilling, the terrifying, the downright bizarre. And honestly? It’s got more plot twists than your average Netflix drama.
Hold Up—Why Should We Even Care About Scientific News Today?
Look, we get it. Between rent hikes, doomscrolling, and figuring out if oat milk curdles in cold brew, scientific news today might feel like background noise. But here’s the tea: science isn’t just “out there.” It’s in your tap water, your Wi-Fi signal, your sneeze during allergy season. Ignoring scientific news today is like driving with your eyes closed—possible for a hot minute, but not sustainable. Plus, staying tuned means you’re not that uncle at Thanksgiving arguing that the moon landing was faked while using a GPS app. Real recognize real, and scientific news today keeps us grounded in what’s actually real.
Peekin’ Under the Hood: What Makes Scientific News Today Tick?
So, what kinda stuff falls under scientific news today? Think breakthroughs (like CRISPR gene edits that could zap hereditary diseases), controversies (AI-generated “science” flooding journals), or urgent warnings (melting permafrost releasing ancient viruses). Scientific news today covers physics, bio, climate, tech—you name it. And it’s not always polished. Sometimes it’s messy, contradictory, and evolving by the hour. That’s not a bug—it’s a feature. Science isn’t a statue; it’s a river. And scientific news today is your life raft.
Wait—Is All This “Scientific News Today” Actually Trustworthy?
Ah, the million-dollar question. With every Tom, Dick, and influencer slapping “SCIENCE!” on a TikTok about cucumber water curing cancer, it’s fair to wonder: which scientific news today can you actually trust? Short answer: look for outlets that cite peer-reviewed studies, name researchers, and say “we don’t know yet” when they don’t know yet. If a headline screams “MIRACLE CURE FOUND!!!” without mentioning phase trials, run. Real scientific news today hums with nuance—it’s not hype; it’s honesty with data. And if it smells like snake oil? It probably is.
What’s Hot in Scientific News Today? Spoiler: It’s Wild
Right now, scientific news today is buzzing like a beehive on espresso. Researchers just spotted potential phosphine plumes on Venus again—could mean microbes, could mean geology gone rogue. Meanwhile, fusion energy labs are hitting net energy gains more consistently, which might finally make “limitless clean power” more than a bumper sticker. And over in bioengineering, scientists grew mini-brains that respond to light like retinas. Yeah, you read that right. Scientific news today isn’t just interesting—it’s rewriting what’s possible before breakfast.
From Lab to Living Room: How Scientific News Today Hits Our Daily Lives
You might think scientific news today stays locked in ivory towers, but nah—it’s already in your kitchen. That non-stick pan? Nano-coating science. Your phone’s facial recognition? Trained on datasets shaped by computer vision research. Even your sourdough starter’s behavior ties into microbiome studies popping up in scientific news today. It’s not abstract—it’s tactile, immediate, and sometimes even tasty. When climate models drop new projections in scientific news today, your insurance rates might shift next month. Science isn’t distant; it’s dinner.
Y’all Ever Notice How Scientific News Today Feels… Overwhelming?
Let’s be real: keeping up with scientific news today can feel like trying to drink from a firehose while riding a unicycle. One day it’s AI ethics, the next it’s asteroid mining. The sheer volume is dizzying. But here’s a hack: don’t try to swallow it all. Pick a lane—climate, health, space—and go deep. Subscribe to one legit newsletter. Follow a few real scientists (not “science communicators” selling crystals). Scientific news today isn’t a test you gotta ace; it’s a conversation you can join at your own pace. Breathe. You got this.
Who’s Actually Reporting Scientific News Today—and Are They Cred?
Not all messengers are created equal when it comes to scientific news today. Outlets like Nature News, ScienceDaily, or Quanta Magazine? Solid. Random blog titled “TruthBlast99”? Less so. Credible scientific news today outlets employ editors with science degrees, fact-check rigorously, and correct errors publicly. They also avoid clickbait like “Scientists Shocked By THIS One Weird Trick!” If a site’s primary goal is ad revenue over accuracy, side-eye it. Good scientific news today journalism is slow, careful, and kind of boring—which is exactly why it’s trustworthy.
What’s the Deal With Pop Sci vs. Real Scientific News Today?
Alright, let’s clear the air. A “popular science article” (aka pop sci) simplifies complex ideas for mass appeal—think Scientific American or a well-scripted YouTube explainer. That’s not bad! But it’s not the same as primary scientific news today reporting, which sticks closer to the original paper or press release. Pop sci might say “Scientists invent teleportation!” while scientific news today says “Team observes quantum state transfer over 2 meters in lab setting.” One’s catchy; the other’s precise. Both have value, but know which you’re reading—your inner nerd will thank you.
So… How Do We Stay Sane While Tracking Scientific News Today?
Look, loving scientific news today doesn’t mean you gotta burn out. Set boundaries. Mute the doom tabs. Remember: science is incremental. Not every headline is an emergency. If you’re feeling swamped, circle back to wonder—not panic. That photo of Jupiter’s storms? That’s scientific news today too. And hey, if you ever need a break from the chaos, Onomy Science’s got your back with grounded takes. Dive into our Journals section for slower burns, or check out our deep dive on Scientific Current Events Global Impact for stories that connect lab benches to living rooms. Stay curious, not frantic.
Frequently Asked Questions
What is the latest discovery in science?
As of late 2025, one of the buzziest entries in scientific news today involves the possible detection of microbial life signatures in Venusian clouds via renewed phosphine observations. Meanwhile, clean fusion reactors are achieving sustained net energy output in multiple labs—a huge leap toward viable fusion power. These stories, among others, dominate scientific news today as humanity inches closer to answering age-old questions about life and energy.
What are current issues in science?
Scientific news today frequently highlights urgent challenges like research reproducibility crises, AI-generated fake studies polluting academic databases, and the politicization of climate or public health data. Equity in science funding and access also remains a hot topic in scientific news today, as marginalized communities push for inclusive research practices. These aren’t just “lab problems”—they shape real-world trust in science itself.
What is a popular science article?
A popular science article translates complex scientific findings into engaging, accessible language for general audiences—without requiring a PhD to decode it. While it’s not a substitute for peer-reviewed literature, it’s a vital bridge in scientific news today. When done right, pop sci fuels public curiosity and democratic discourse, making scientific news today feel less like a lecture and more like a campfire story about the universe.
What is science alert news?
“Science alert news” typically refers to urgent or breaking updates in the scientific world—like sudden disease outbreaks, major climate tipping points, or unexpected space phenomena. These alerts are a high-priority slice of scientific news today, designed to inform policymakers and the public quickly. While outlets like ScienceAlert.com popularized the term, the concept lives wherever scientific news today meets immediacy and impact.
References
- https://www.nature.com/news
- https://www.sciencedaily.com
- https://www.quantamagazine.org
- https://www.scientificamerican.com






